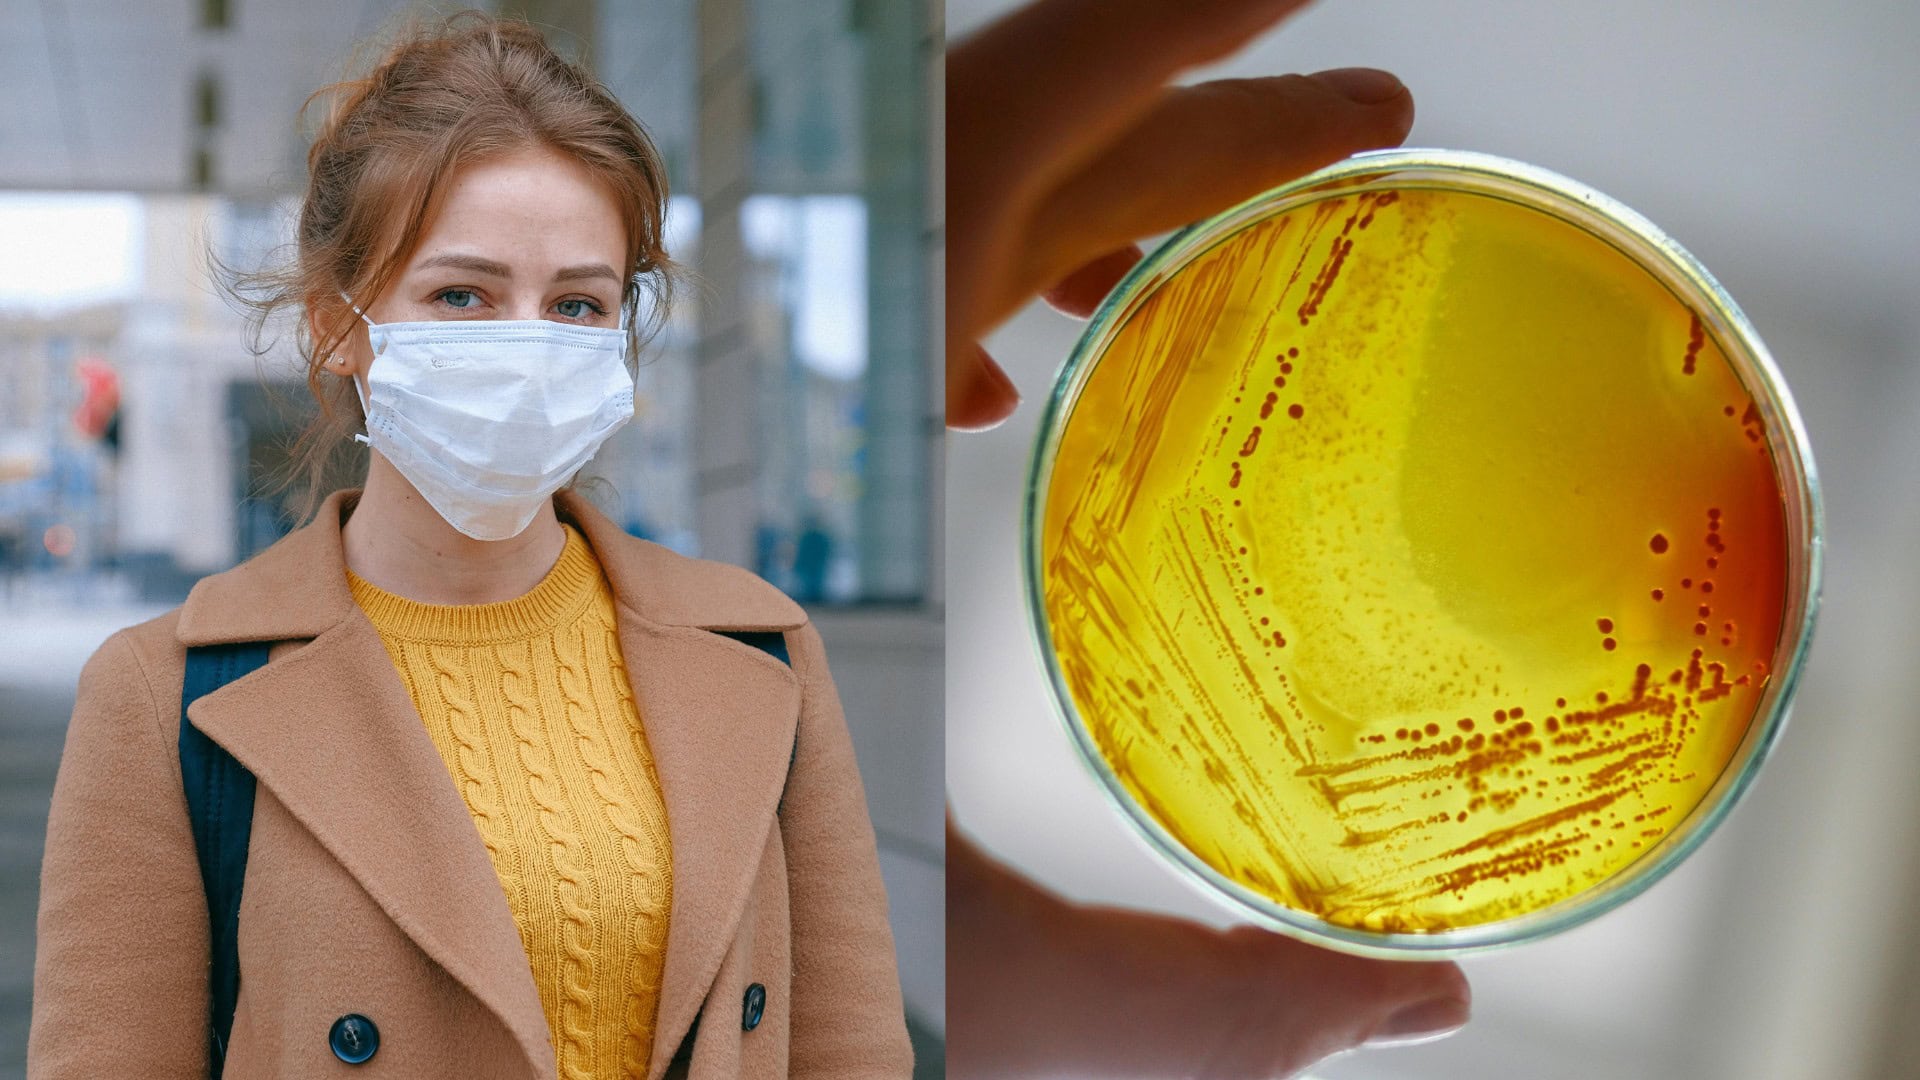
na snimke je bakteria, mor, chripka

Smrtiaca baktéria spôsobila už 3 pandémie a stále nezmizla. Vedci zistili, ako sa pred ňou ochrániť
- Smrtiaca baktéria spôsobila už 3 pandémie
- Nejde len o krutú minulosť, je tu s nami dodnes
- Takto sa pred ňou môžeš chrániť
Keď sa povie slovo „mor“, mnohým sa vybaví obraz temného stredoveku, tiel na uliciach a ľudí v rúchach s vtáčími maskami.
No len málokto si uvedomuje, že tá istá baktéria, ktorá v priebehu dejín pripravila o život desiatky miliónov ľudí, z planéty nikdy nezmizla. Naopak, ticho prežíva dodnes – a vedci stále skúmajú, ako sa jej to podarilo.
Baktéria s názvom Yersinia pestis sa zapísala do dejín ako pôvodca troch najničivejších pandémií, aké ľudstvo zažilo. Prvý raz udrela počas justiniánskeho moru v 6. storočí, potom sa v 14. storočí stala symbolom čiernej smrti a napokon sa vrátila počas tretej pandémie v 19. storočí. Vedci dlho hľadali odpoveď na otázku, ako sa tento patogén dokázal udržať v populácii tak dlho a zároveň opakovane vyvolať katastrofu globálneho rozsahu.
Vedci rozlúštili jej evolučný trik
Nedávna štúdia publikovaná v prestížnom vedeckom časopise Science prináša nové svetlo do temnej histórie tejto baktérie. Výskumníci z McMaster University a Institut Pasteur skúmali stovky vzoriek Y. pestis zo staroveku, stredoveku aj novoveku. Z ich analýzy vyplynulo, že baktéria si počas stáročí osvojila zaujímavú stratégiu prežitia – postupne znižovala svoju virulenciu. Inými slovami, stávala sa menej smrtiacou, no o to odolnejšou a prispôsobivejšou.
Menej smrteľná, no odolnejšia
Kľúčovým prvkom tejto evolučnej stratégie bol gén s názvom pla, ktorý zohráva dôležitú úlohu pri schopnosti baktérie šíriť sa v tele hostiteľa. Vedci zistili, že v priebehu histórie sa počet kópií tohto génu znižoval. Zatiaľ čo staršie kmene mali tento gén vo viacerých kópiách a spôsobovali rýchlo postupujúce a často smrteľné infekcie, neskoršie varianty baktérie s menej kópiami pla viedli k miernejšiemu priebehu choroby.
Tento fakt paradoxne umožnil hostiteľom žiť dlhšie, čo predĺžilo čas, počas ktorého sa mohla nákaza šíriť na ďalších ľudí alebo zvieratá. Experimenty vykonané na laboratórnych myšiach ukázali, že pri infekcii baktériami s viacerými kópiami génu pla dochádza k rýchlej smrti hostiteľa. Naopak, myši infikované variantom so zníženým počtom kópií prežívali dlhšie a baktéria sa v ich tele stabilne udržiavala.
Prirodzenými hostiteľmi Yersinie pestis sú predovšetkým hlodavce, najmä potkany, a k prenosu na človeka dochádza prostredníctvom bĺch. Zníženie virulencie zabezpečilo, že infikované hlodavce neumierali tak rýchlo, čím sa predĺžil čas, počas ktorého mohli baktériu šíriť.

Mor dnes už vieme liečiť
Hoci mor dnes nepatrí medzi rozšírené choroby, úplne nezmizol. Každoročne sa objavujú ojedinelé prípady v regiónoch ako Madagaskar, Demokratická republika Kongo, Uganda, Mongolsko a dokonca aj v niektorých oblastiach USA, ako je Nové Mexiko. Moderná medicína však pokročila natoľko, že infekcia sa dá pri včasnej diagnostike úspešne liečiť antibiotikami. Problém nastáva vtedy, keď sa ochorenie nerozpozná včas – v takých prípadoch môže byť priebeh stále veľmi nebezpečný.
Vedci upozorňujú, že ochrana pred morom je stále aktuálnou témou v oblastiach s výskytom tejto baktérie. Základom prevencie zostáva sledovanie populácií hlodavcov a zabezpečenie hygieny v prostredí, kde sa človek dostáva do kontaktu s potenciálnymi prenášačmi. Rovnako dôležité sú aj osveta a pripravenosť lekárov rozpoznať príznaky. Mor sa síce môže prejaviť rôznymi formami, no včasné podanie antibiotík dramaticky zvyšuje šancu na úplné zotavenie.
Dôležitú úlohu zohráva aj zvyšovanie hygienických štandardov, správne skladovanie potravín a obmedzenie kontaktu ľudí s voľne žijúcimi zvieratami. Okrem toho je nevyhnutná aj osveta – verejnosť by mala vedieť, že mor stále existuje a rozpoznať jeho príznaky. Aj keď ide o zriedkavé prípady, mor sa môže prejaviť v rôznych formách – bubonickej, septickej alebo pľúcnej.
Čítaj viac z kategórie: Štúdie, prieskumy a analýzy
Zdroj: Science










